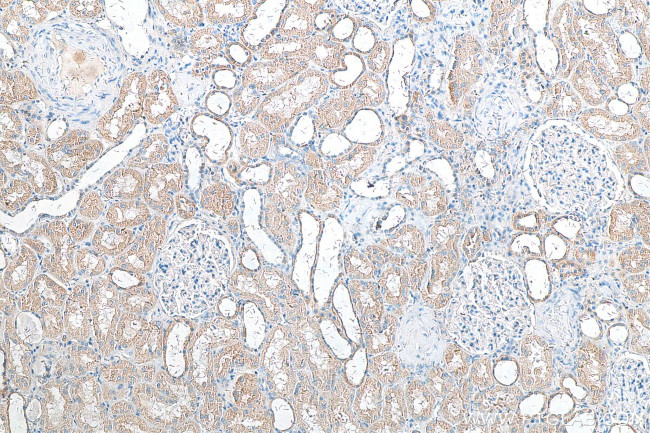
CWF19L2 Antibody in Immunohistochemistry (Paraffin) (IHC (P))

Search
Proteintech
CWF19L2 Polyclonal Antibody
{{$productOrderCtrl.translations['antibody.pdp.commerceCard.promotion.promotions']}}
{{$productOrderCtrl.translations['antibody.pdp.commerceCard.promotion.viewpromo']}}
{{$productOrderCtrl.translations['antibody.pdp.commerceCard.promotion.promocode']}}: {{promo.promoCode}} {{promo.promoTitle}} {{promo.promoDescription}}. {{$productOrderCtrl.translations['antibody.pdp.commerceCard.promotion.learnmore']}}
产品信息
24872-1-AP
种属反应
宿主/亚型
分类
类型
抗原
偶联物
形式
浓度
规格
纯化类型
保存液
内含物
保存条件
运输条件
产品详细信息
Immunogen sequence: VILVRTDQS GRVWPVNTPG KSLESQGGRR KRQMVSTHEK RERVRYFHDD DNLSLNDLVK NEKMGTAENQ NKLFMRMASK FMGKTDGDYY TLDDMFVSKA AERERLGEEE ENQRKKAIAE HRSLAAQMEK CLYCFDSSQF PKHLIVAIGV KVYLCLPNVR SLTEGHCLIV PLQHHRAATL LDEDIWEEIQ MFRKSLVKMF EDKGLDCIFL ETNMSMKKQY HMVYECIPLP KEVGDMAPIY FKKAIMESDE EWSMNKKLID LSSKDIRKSV PRGLPYFSVD FGLHGGFAHV IEDQHKFPHY FGKEIIGGML DIEPRLWRKG IRESFEDQRK KALQFAQWWK PYDFTKSKNC (546-894 aa encoded by BC110442)
靶标信息
CWF19L2 is a protein coding gene.
仅用于科研。不用于诊断过程。未经明确授权不得转售。
篇参考文献 (0)
生物信息学
蛋白别名: CWF19 like 2, cell cycle control; CWF19-like protein 2; FLJ32343; unnamed protein product
基因别名: CWF19L2
UniProt ID: (Human) Q2TBE0
Entrez Gene ID: (Human) 143884